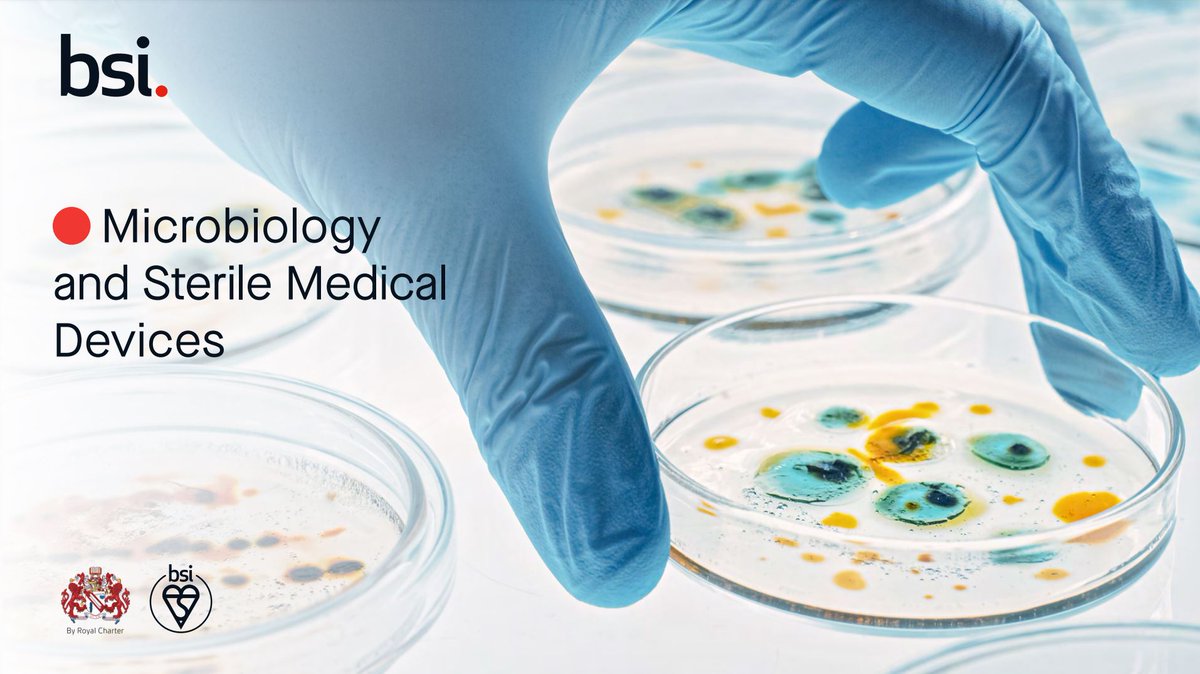
Soeben erschienen! Unsere neue #Broschüre über #Mikrobiologie und #sterile #Medizinprodukte. Entdecken Sie unsere Services für #sterileMedizinprodukte, wie Sie sich auf ein mikrobiologisches #Audit vorbereiten und vieles mehr!
Hier weiterlesen: bit.ly/3r7VMN3

BSI Germany
@bsi_germany
BSI ist Ihr Partner für Schulung und Zertifizierung von Management-Standards, wir helfen Unternehmen weltweit Excellenz zur Gewohnheit werden zu lassen.
ID: 1596081553
https://www.bsigroup.com/de-DE/ 15-07-2013 15:08:53
777 Tweet
659 Followers
663 Following